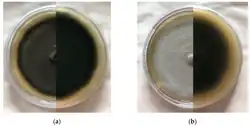

Esteya
| Esteya | |
|---|---|
| Scientific classification | |
| Kingdom: | Fungi |
| Division: | Ascomycota |
| Class: | Sordariomycetes |
| Order: | Ophiostomatales |
| Family: | Ophiostomataceae |
| Genus: | J.Y.Liou, J.Y.Shih & Tzean, 1999[1] |
| Type species | |
| Esteya vermicola J.Y.Liou, J.Y.Shih & Tzean
| |
Esteya is a genus of nematophagous fungi in the order Ophiostomatales, notable for their ability to parasitize and kill nematodes, particularly the pinewood nematode, Bursaphelenchus xylophilus—a major pest in forestry and causal agent of pine wilt disease. The genus belongs to the family Ophiostomataceae and includes two species, E. vermicola and E. floridanum.
Distribution
Esteya vermicola is a cosmopolitan species that was reported in Brazil,[2] China,[3] the Czech Republic,[4] Italy, Japan, South Korea,[5] and Taiwan.[6] Esteya floridanum was isolated in the United States of America.[7]
Morphology and life cycle
Macroscopically, E. vermicola colonies appear greyish-green to dark-green and reverse dark-grey to olive-green after being cultured for 7 days on rich media, although slight variations have also been observed: grayish-blue with slight white on the surface and reverse dark-grey to chartreuse, white at first, gradually turning grayish-green and dark-green with dark-brown pigments.[6][2][4]
In similar conditions, E. floridanum colonies appear initially white, turning light-grey after 5 days, and reverse initially white, switching to dark-brown on potato dextrose agar and beige on malt extract agar.[7]
_Figure_10.jpg)
Species in the Esteya genus are characterized by the production of lunate conidia (asexual spores), distinctive adhesive structures that attach to nematodes and play a role in the infective cycle.[6] After adhesion, the conidia usually germinate within 18–24 h, killing the nematode when organs and tissues are destroyed by a mass of hyphae, and producing more lunate conidia to begin the cycle anew.[8]
Phylogenetics
Esteya species have frequently been isolated from insects.[9][10] Molecular evidence reveals a close evolutionary relationship with insect-associated fungi, particularly ambrosial fungi from the Raffaelea sulphurea complex, recently reclassified as Dryadomyces.[11] Esteya species also cluster phylogenetically with other ophiostomatoid fungi,[7][11][12] some of which are part of the pine wilt disease system.
Ecology
Considering their close association with insects, Esteya species likely play an important role in coniferous ecosystems by potentially regulating pinewood nematode populations. Furthermore, despite their slow-growing nature, they were found to be able to compete with fungi occurring in the pathosystem of pine wilt disease under controlled conditions.[12] This knowledge directly impacts biocontrol strategies, as competition with other microorganisms could hinder the establishment of Estraya species within symptomatic pine trees.
Biocontrol potential
Due to its specificity and effectiveness against B. xylophilus, E. vermicola has been investigated as a biological control agent. It can be applied both prophylactically and to infected pine trees, and research has demonstrated its ability to suppress nematode populations and reduce disease severity under laboratory and semi-natural conditions.[13][14]
Research and applications
The genome of E. vermicola has been sequenced,[15][16] offering insights into its pathogenic mechanisms against nematodes.[17] Its dual lifestyle—as both an endophyte in trees and a parasite of nematodes—makes it a subject of interest in fungal ecology, plant pathology, and sustainable pest management, especially against B. xylophilus.[18] Ongoing research is focused on improving its formulation, delivery, and field deployment.[19]
References
- ^ "Esteya J.Y.Liou, J.Y.Shih & Tzean, 1999". Global Biodiversity Information Facility. Retrieved 26 May 2025.
- ^ a b Wang, X.; Wang, T.; Wang, J.; Guan, T.; Li, H. (2014). "Morphological, molecular and biological characterization of Esteya vermicola, a nematophagous fungus isolated from intercepted wood packing materials exported from Brazil". Mycoscience. 55 (5): 367–377. doi:10.1016/j.myc.2014.01.002.
- ^ Wang, H.M.; Wang, Z.; Liu, F.; Wu, C.X.; Zhang, S.F.; Kong, X.B.; Decock, C.; Lu, Q.; Zhang, Z. (2019). "Differential patterns of ophiostomatoid fungal communities associated with three sympatric Tomicus species infesting pines in south-western China, with a description of four new species". MycoKeys (50): 93–133. doi:10.3897/mycokeys.50.32653. PMC 6477840. PMID 31043857.
- ^ a b Kubátová, A.; Novotný, D.; Prášil, K.; Mráček, Z. (2000). "The nematophagous hyphomycete Esteya vermicola found in the Czech Republic". Czech Mycology. 52 (3): 227–235. doi:10.33585/cmy.52305.
- ^ Wang, C.Y.; Fang, Z.M.; Wang, Z.; Gu, L.J.; Sun, B.S.; Zhang, D.L.; Sung, C.K. (2009). "High infection activities of two Esteya vermicola isolates against pinewood nematode". African Journal of Microbiology Research. 3: 581–584.
- ^ a b c Liou, J.Y.; Shih, J.Y.; Tzean, S.S. (1999). "Esteya, a new nematophagous genus from Taiwan, attacking the pinewood nematode (Bursaphelenchus xylophilus)". Mycological Research. 103 (2): 242–248. doi:10.1017/S0953756298006984.
- ^ a b c Li, Y.; Yu, H.; Araújo, J.; Zhang, X.; Ji, Y.; Hulcr, J. (2021). "Esteya floridanum sp. nov.: An Ophiostomatalean nematophagous fungus and its potential to control the pine wood nematode". Phytopathology. 111 (7): 304–311. Bibcode:2021PhPat.111..304L. doi:10.1094/PHYTO-06-20-0229-R. PMID 32734814.
- ^ Wang, H.; Wang, B.; Yin, C.; Gao, J.; Tao, R.; Sun, L.; Wang, Y.; Wang, Z.; Li, X.; Sung, K. (2020). "In vivo infection of Bursaphelenchus xylophilus by the fungus Esteya vermicola". Pest Management Science. 76 (8): 2854–2864. doi:10.1002/ps.5839. PMID 32237055.
- ^ Chu, W.H.; Dou, Q.; Chu, H.; Wang, H.H.; Sung, C.; Wang, C. (2015). "Research advance on Esteya vermicola, a high potential biocontrol agent of pine wilt disease". Mycological Progress. 14 (12): 115. Bibcode:2015MycPr..14..115C. doi:10.1007/s11557-015-1137-9.
- ^ Pires, D.; Vicente, C. S. L.; Inácio, M. L.; Mota, M. (2022). "The Potential of Esteya spp. for the Biocontrol of the Pinewood Nematode, Bursaphelenchus xylophilus". Microorganisms. 10 (1): 168. doi:10.3390/microorganisms10010168. PMC 8781088. PMID 35056617.
- ^ a b de Beer, Z. W.; Procter, M.; Wingfield, M. J.; Marincowitz, S.; Duong, T. A. (2022). "Generic boundaries in the Ophiostomatales reconsidered and revised". Studies in Mycology. 101: 57–120. doi:10.3114/sim.2022.101.02. PMC 9365045. PMID 36059894.
- ^ a b Pires, D.; Vicente, C.S.L.; Mota, M.; Inácio, M.L. (2024). "Polyphasic approach to the selection of Esteya isolates for the control of the pinewood nematode, Bursaphelenchus xylophilus". Fungal Biology. 128 (8): 2242–2249. Bibcode:2024FunB..128.2242P. doi:10.1016/j.funbio.2024.10.001. hdl:10174/37500. PMID 39643391.
- ^ Wang, Z.; Zhang, Y.; Wang, C.; Wang, Y.; Sung, C. (2017). "Esteya vermicola Controls the Pinewood Nematode, Bursaphelenchus xylophilus, in Pine Seedlings". Journal of Nematology. 49 (1): 86–91. doi:10.21307/jofnem-2017-048. PMC 5411257. PMID 28512380.
- ^ Wang, C.Y.; Yin, C.; Fang, Z.M.; Wang, Z.; Wang, Y.B.; Xue, J.J.; Sung, C.K. (2018). "Using the nematophagous fungus Esteya vermicola to control the disastrous pine wilt disease". Biocontrol Science and Technology. 28 (3): 268–277. Bibcode:2018BioST..28..268W. doi:10.1080/09583157.2018.1441369.
- ^ Wang, R.; Dong, L.; Chen, Y.; Qu, L.; Li, E.; Wang, Q.; Zhang, Y. (2017). "The complete mitochondrial genome of nematophagous fungus Esteya vermicola". Mitochondrial DNA Part B. 2 (1): 196–197. doi:10.1080/23802359.2017.1307700. PMC 7799536. PMID 33473766.
- ^ Wang, R.; Dong, L.; Chen, Y.; Wang, S.; Qu, L. (2022). "Third Generation Genome Sequencing Reveals That Endobacteria in Nematophagous Fungi Esteya vermicola Contain Multiple Genes Encoding for Nematicidal Proteins". Frontiers in Microbiology. 13: 842684. doi:10.3389/fmicb.2022.842684. PMC 9111515. PMID 35591989.
- ^ Hu, Z.; Chen, C.; Zheng, X.; Yuan, J.; Zou, R.; Xie, C. (2024). "Establishing Gene Expression and Knockout Methods in Esteya vermicola CBS115803". Molecular Biotechnology. 66 (10): 2872–2881. doi:10.1007/s12033-023-00898-6. PMID 37777998.
- ^ Wang, H.; Sun, Y.; Yin, C.; Gao, J.; Hu, J.; Sung, C.; Wang, C.; Wang, Z. (2024). "Unraveling the interactions of Esteya vermicola, pinewood nematode, and pine hosts: Insights into population dynamics and molecular responses". Chemosphere. 363: 142948. Bibcode:2024Chmsp.36342948W. doi:10.1016/j.chemosphere.2024.142948. PMID 39059633.
- ^ Zhang, L.; Li, Y.; Wen, X.; Wang, X.; Zhang, W.; Li, D.; Feng, Y.; Liu, Z.; Zhang, X. (2025). "Screening and Optimization of Solid-State Fermentation for Esteya vermicola, an Entomopathogenic Fungus Against the Major Forest Pest Pine Wood Nematode". Microorganisms. 13 (2): 434. doi:10.3390/microorganisms13020434. PMC 11858419. PMID 40005800.